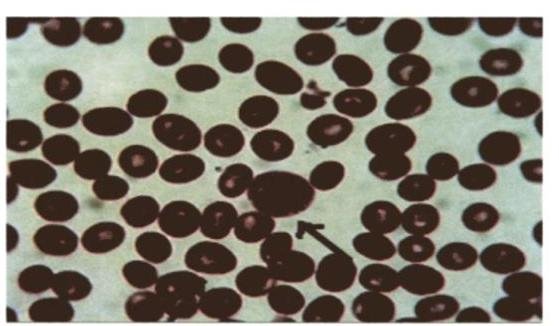
Imagen img-0.jpeg

PDF Processor
Inicio
Editar documento
Editar documento: 4. Anemias Megaloblásticas (Deficienica Ácido Fólico, Vitamina B12, Perniciosa)
Título
Contenido mejorado
Contenido original
Contenido mejorado por IA (Markdown)
# ANEMIAS MEGALOBLÁSTICAS ## DEFINICIÓN Las anemias megaloblásticas, son causadas por una deficiencia de de Vitamina B12 o Folato (ácido fólico) y tienen en común una ALTERACIÓN EN LA SÍNTESIS DE ADN, ya que tanto el folato como la vitamina B12 participan en una reacción necesaria para la síntesis de dicho ADN, que consiste en la formación de TIMIDILATO a partir del URIDILATO. La transfusión de concentrados de hematíes no está indicada en este tipo de anemias. ## FISIOPATOLOGÍA 1. Por la disminución de la velocidad de síntesis de ADN, se produce una multiplicación celular lenta, persistiendo un desarrollo citoplasmático normal. 2. Esta alteración provoca cambios morfológicos característicos de las anemias megaloblásticas 3. Gran tamaño de los precursores de las células sanguíneas en MO y SP. 4. ERITROPOYESIS INEFICAZ - celularidad medular aumentada, pero producción de eritrocitos disminuida 5. También puede haber pancitopenia. ## SANGRE PERIFÉRICA - HEMATÍES DE GRAN TAMAÑO (Macroovalocitos) - Aumento de VCM y HCM - Neutrófilos hipersegmentados - Los reticulocitos NO se encuentran aumentados al diagnóstico, pero sí al instaurar el tratamiento (en la fase de recuperación). - ELEVACIÓN DE DHL sérica como consecuencia de células hematopoyéticas en la médula ósea (eritropoyesis ineficaz) ## MÉDULA ÓSEA 1. Crecimiento en el tamaño de los precursores hematopoyéticos (maduración Megaloblástica) 2. Aumento de la población mielopoyética y hematopoyética (por retardo de la división celular)  # ANEMIA DÉFICIT ÁCIDO FÓLICO Es la causa más frecuente de Anemias Megaloblásticas; el ácido fólico se encuentra disponible para consumo en productos cárnicos, verduras, legumbres, levaduras y frutos secos. (también llamado VITAMINA B9) Es la causa más frecuente de anemia Megaloblástica. ## METABOLISMO 1) El ácido fólico denominado - PTEROIL MONOGLUTÁMICO. a. Forma inactiva que precisa activarse por la acción de - FOLATO REDUCTASAS b. Forma activa - ÁCIDO TETRAHIDROFÓLICO / ÁCIDO FOLÍNICO. Ácido Fólico SE ASORBE EN - YEYUNO SE ALMACENA HÍGADO. ## ETIOLOGÍA | DISMINUCIÓN DE APORTE | Desnutrición, etilismo | | :--: | :-- | | DISMINUCIÓN DE ABSORCIÓN | Enteropatías y fármacos | | AUMENTO DE CONSUMO | Embarazo, infancia, hemopoyesis hiperactiva, hipertiroidismo. | | ACTIVACIÓN BLOQUEADA DE FOLATOS | Metotrexato, trimetoprim, hidantoínas, barbitúricos | | INCREMENTO DE PÉRDIDAS | Enteropatía pierde-proteínas, hemodialis. | ## OLÍNICA - La misma que la deficiencia de Cobalamina - Aquí no se observan trastornos neurológicos, (Ácido fólico no es necesario para la síntesis de mielina). ## DIAGNÓSTICO 1. Disminución FOLATO SÉRICO (-4 ng/mL) 2. Disminución folato intraeritrocitoario ( -100 ng / ml ) ## TRATAMIENTO 1. Administración de ÁCIDO FÓLICO V.O. 1 MG CADA 24 HORAS. 2. Se debe cambiar vía parenteral si no existe respuesta Si se trata de anemia por alteración en las Folato Reductasas - ÁCIDO FOLÍNICO # ANEMIA DEFICIENCIA VITAMINA B12 ## METABOLISMO La Vitamina B12 o Cobalamina aparece en ALIMENTOS DE ORIGEN ANIMAL, sus niveles normales son elevados, por lo que la deficiencia puede tardar años en producirse. El ÁCIDO CLORHÍDRICO Y LA PEPSINA produce una liberación de la Cobalamina de las proteínas del alimento. Vit B12 se une al factor intrínseco (producido por células parietales gástricas) La Vit B12 es transportada por todo el intestino delgado HASTA EL ÍLEON TERMINAL. Se ABSORBE hacia el plasma en ÍLEON TERMINAL por receptores específicos En sangre la Vit B12 está unida a la transcobalamina (sintetizada en hígado). ## ETIOLOGÍA | DISMINUCIÓN DE INGESTA | Dietas vegetarianas estrictas | | :-- | :-- | | | Deficiencia de factor intrínseco: gastrectomía, anemia perniciosa (causa más frecuente de malabsorción de Vitamina B12). | | DISMINUCIÓN DE LA ABSORCIÓN | Alteración intestinal: sobre todo íleon terminal (esprue tropical, enfermedad celiaca, enteritis regional, resección intestinal. | | | Fármacos: Biguanidas, AntiH2, colchicina, Neomicina, ácido aminosalicílico. | | ALTERACIÓN EN LA UTILIZACIÓN | Inactivación del Vit B12 de almacén mediante el óxido nitroso de la anestesia. | ## CLÍNICA - Alteración más característica - DEGENERACIÓN COMBINADA SUBAGUDA MEDULAR - Se producen alteraciones en los cordones laterales y posteriores de la medula espinal, manifestadas por alteración de la sensibilidad vibratoria y propioceptiva - Alteraciones básicas de la serie roja y también de las otras series - ALTERACIÓN NEUROPSIQUIATRICA - por deficiencia de Vitamina B12. Fases avanzadas - Demencia # DIAGNÓSTICO 1. ANEMIA MEGALOBLÁSTICA 2. Determinación sérica de Vitamina B12 3. Homocisteína y Ácido Metilmalónico Aumentado 4. Incremento en eliminación urinaria de ácido metilmalónico ## TRATAMIENTO - Tratar causa subyacente - Administración de Vitamina B12 intramuscular - Respuesta reticular al 49 -- 5 o día. - Se aconseja administrar Ácido Fólico (la deficiencia de Cobalamina ocasiona a su vez un déficit intracelular de folato). # ANEMIA PERNICIOSA También llamada Enfermedad de Addison-Biermer, es la cual más frecuente de malabsorción de Vitamina B12. ## MALABSORCIÓN VITAMINA B12 ## ETIOLOGÍA El defecto es una atrofia crónica de la mucosa gástrica oxíntica (células parietales), de origen autoinmunitario que conduce a una ausencia de secreción de factor intrínseco y ácido clorhídrico. - Destrucción autoinmunitaria de células parietales gástricas, objetivándose en el suero del 90% de los pacientes ANTICUERPOS IgG contra células parietales y Ac contra el Factor Intrínseco. - La anemia perniciosa es un proceso premaligno, por lo que es necesario dar seguimiento de Ca Gástrico. ## EPIDEMIOLOGÍA - Mayores de 60 años - Anemia perniciosa juvenil \rightarrow 10-20 años - Se observa en Europa y África. ## CLÍNICA - Anemia de comienzo insidioso que empeora lentamente. - Aclorhidria - disminución de absorción del hierro de los alimentos. ## DIAGNÓSTICO 1. Determinación sérica de Vitamina B12 2. Determinación de anticuerpos anti-célula parietal gástrica y Factor Intrínseco 3. PREUBA DE SCHILLING - puede observarse absorción de B12 al añadir Factor Intrínseco. ## TRATAMIENTO - Administración de Vitamina B12 parenteral. - Hidroxicobalamina hasta corregir la anemia.
Vista previa
Contenido original (Markdown)
# ANEMIAS MEGALOBLÁSTICAS ## DEFINICIÓN Las anemias megaloblásticas, son causadas por una deficiencia de de Vitamina B12 o Folato (ácido fólico) y tienen en común una ALTERACIÓN EN LA SÍNTESIS DE ADN, ya que tanto el folato como la vitamina B12 participan en una reacción necesaria para la síntesis de dicho ADN, que consiste en la formación de TIMIDILATO a partir del URIDILATO. La transfusión de concentrados de hematíes no está indicada en este tipo de anemias. ## FISIOPATOLOGÍA 1. Por la disminución de la velocidad de síntesis de ADN, se produce una multiplicación celular lenta, persistiendo un desarrollo citoplasmático normal. 2. Esta alteración provoca cambios morfológicos característicos de las anemias megaloblásticas 3. Gran tamaño de los precursores de las células sanguíneas en MO y SP. 4. ERITROPOYESIS INEFICAZ - celularidad medular aumentada, pero producción de eritrocitos disminuida 5. También puede haber pancitopenia. ## SANGRE PERIFÉRICA - HEMATÍES DE GRAN TAMAÑO (Macroovalocitos) - Aumento de VCM y HCM - Neutrófilos hipersegmentados - Los reticulocitos NO se encuentran aumentados al diagnóstico, pero sí al instaurar el tratamiento (en la fase de recuperación). - ELEVACIÓN DE DHL sérica como consecuencia de células hematopoyéticas en la médula ósea (eritropoyesis ineficaz) ## MÉDULA ÓSEA 1. Crecimiento en el tamaño de los precursores hematopoyéticos (maduración Megaloblástica) 2. Aumento de la población mielopoyética y hematopoyética (por retardo de la división celular) # ANEMIA DÉFICIT ÁCIDO FÓLICO Es la causa más frecuente de Anemias Megaloblásticas; el ácido fólico se encuentra disponible para consumo en productos cárnicos, verduras, legumbres, levaduras y frutos secos. (también llamado VITAMINA B9) Es la causa más frecuente de anemia Megaloblástica. ## METABOLISMO 1) El ácido fólico denominado - PTEROIL MONOGLUTÁMICO. a. Forma inactiva que precisa activarse por la acción de - FOLATO REDUCTASAS b. Forma activa - ÁCIDO TETRAHIDROFÓLICO / ÁCIDO FOLÍNICO. Ácido Fólico SE ASORBE EN - YEYUNO SE ALMACENA HÍGADO. ## ETIOLOGÍA | DISMINUCIÓN DE APORTE | Desnutrición, etilismo | | :--: | :-- | | DISMINUCIÓN DE ABSORCIÓN | Enteropatías y fármacos | | AUMENTO DE CONSUMO | Embarazo, infancia, hemopoyesis hiperactiva, hipertiroidismo. | | ACTIVACIÓN BLOQUEADA DE FOLATOS | Metotrexato, trimetoprim, hidantoínas, barbitúricos | | INCREMENTO DE PÉRDIDAS | Enteropatía pierde-proteínas, hemodialis. | ## OLÍNICA - La misma que la deficiencia de Cobalamina - Aquí no se observan trastornos neurológicos, (Ácido fólico no es necesario para la síntesis de mielina). ## DIAGNÓSTICO 1. Disminución FOLATO SÉRICO (-4 ng/mL) 2. Disminución folato intraeritrocitoario ( -100 ng / ml ) ## TRATAMIENTO 1. Administración de ÁCIDO FÓLICO V.O. 1 MG CADA 24 HORAS. 2. Se debe cambiar vía parenteral si no existe respuesta Si se trata de anemia por alteración en las Folato Reductasas - ÁCIDO FOLÍNICO # ANEMIA DEFICIENCIA VITAMINA B12 ## METABOLISMO La Vitamina B12 o Cobalamina aparece en ALIMENTOS DE ORIGEN ANIMAL, sus niveles normales son elevados, por lo que la deficiencia puede tardar años en producirse. El ÁCIDO CLORHÍDRICO Y LA PEPSINA produce una liberación de la Cobalamina de las proteínas del alimento. Vit B12 se une al factor intrínseco (producido por células parietales gástricas) La Vit B12 es transportada por todo el intestino delgado HASTA EL ÍLEON TERMINAL. Se ABSORBE hacia el plasma en ÍLEON TERMINAL por receptores específicos En sangre la Vit B12 está unida a la transcobalamina (sintetizada en hígado). ## ETIOLOGÍA | DISMINUCIÓN DE INGESTA | Dietas vegetarianas estrictas | | :-- | :-- | | | Deficiencia de factor intrínseco: gastrectomía, anemia perniciosa (causa más frecuente de malabsorción de Vitamina B12). | | DISMINUCIÓN DE LA ABSORCIÓN | Alteración intestinal: sobre todo íleon terminal (esprue tropical, enfermedad celiaca, enteritis regional, resección intestinal. | | | Fármacos: Biguanidas, AntiH2, colchicina, Neomicina, ácido aminosalicílico. | | ALTERACIÓN EN LA UTILIZACIÓN | Inactivación del Vit B12 de almacén mediante el óxido nitroso de la anestesia. | ## CLÍNICA - Alteración más característica - DEGENERACIÓN COMBINADA SUBAGUDA MEDULAR - Se producen alteraciones en los cordones laterales y posteriores de la medula espinal, manifestadas por alteración de la sensibilidad vibratoria y propioceptiva - Alteraciones básicas de la serie roja y también de las otras series - ALTERACIÓN NEUROPSIQUIATRICA - por deficiencia de Vitamina B12. Fases avanzadas - Demencia # DIAGNÓSTICO 1. ANEMIA MEGALOBLÁSTICA 2. Determinación sérica de Vitamina B12 3. Homocisteína y Ácido Metilmalónico Aumentado 4. Incremento en eliminación urinaria de ácido metilmalónico ## TRATAMIENTO - Tratar causa subyacente - Administración de Vitamina B12 intramuscular - Respuesta reticular al 49 -- 5 o día. - Se aconseja administrar Ácido Fólico (la deficiencia de Cobalamina ocasiona a su vez un déficit intracelular de folato). # ANEMIA PERNICIOSA También llamada Enfermedad de Addison-Biermer, es la cual más frecuente de malabsorción de Vitamina B12. ## MALABSORCIÓN VITAMINA B12 ## ETIOLOGÍA El defecto es una atrofia crónica de la mucosa gástrica oxíntica (células parietales), de origen autoinmunitario que conduce a una ausencia de secreción de factor intrínseco y ácido clorhídrico. - Destrucción autoinmunitaria de células parietales gástricas, objetivándose en el suero del 90% de los pacientes ANTICUERPOS IgG contra células parietales y Ac contra el Factor Intrínseco. - La anemia perniciosa es un proceso premaligno, por lo que es necesario dar seguimiento de Ca Gástrico. ## EPIDEMIOLOGÍA - Mayores de 60 años - Anemia perniciosa juvenil \rightarrow 10-20 años - Se observa en Europa y África. ## CLÍNICA - Anemia de comienzo insidioso que empeora lentamente. - Aclorhidria - disminución de absorción del hierro de los alimentos. ## DIAGNÓSTICO 1. Determinación sérica de Vitamina B12 2. Determinación de anticuerpos anti-célula parietal gástrica y Factor Intrínseco 3. PREUBA DE SCHILLING - puede observarse absorción de B12 al añadir Factor Intrínseco. ## TRATAMIENTO - Administración de Vitamina B12 parenteral. - Hidroxicobalamina hasta corregir la anemia.
Vista previa
Cancelar
Guardar cambios